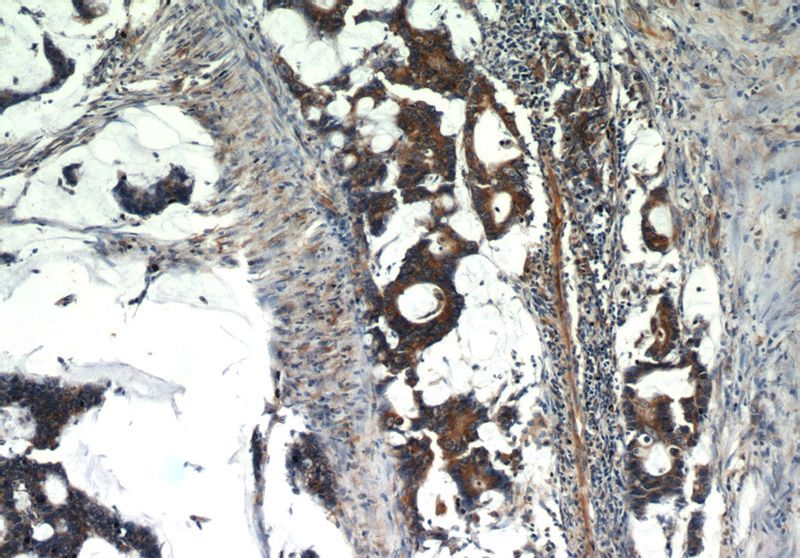
Immunohistochemistry of paraffin-embedded human colon cancer slide using Catalog No:112300(LPCAT1 Antibody) at dilution of 1:100

-
Product Name
LPCAT1 antibody
- Documents
-
Description
LPCAT1 Rabbit Polyclonal antibody. Positive IHC detected in human colon cancer tissue, human lung cancer tissue. Positive IF detected in MCF-7 cells. Positive IP detected in mouse brain tissue. Positive WB detected in human lung tissue, mouse brain tissue, mouse lung tissue, mouse spleen tissue, rat brain tissue, rat lung tissue. Observed molecular weight by Western-blot: 59 kDa
-
Tested applications
ELISA, IF, WB, IP, IHC
-
Species reactivity
Human, Mouse, Rat; other species not tested.
-
Alternative names
Acyltransferase like 2 antibody; AYTL2 antibody; FLJ12443 antibody; FLJ41609 antibody; LPC acyltransferase 1 antibody; lpcat antibody; LPCAT 1 antibody; LPCAT1 antibody; Lyso PAF acetyltransferase antibody; LysoPAFAT antibody; LysoPC acyltransferase 1 antibody; PFAAP3 antibody
-
Isotype
Rabbit IgG
-
Preparation
This antibody was obtained by immunization of LPCAT1 recombinant protein (Accession Number: BC020166). Purification method: Antigen affinity purified.
-
Clonality
Polyclonal
-
Formulation
PBS with 0.02% sodium azide and 50% glycerol pH 7.3.
-
Storage instructions
Store at -20℃. DO NOT ALIQUOT
-
Applications
Recommended Dilution:
WB: 1:1000-1:10000
IP: 1:1000-1:10000
IHC: 1:20-1:200
IF: 1:10-1:100
-
Validations

human lung tissue were subjected to SDS PAGE followed by western blot with Catalog No:112300(LPCAT1 antibody) at dilution of 1:4000
Immunohistochemistry of paraffin-embedded human colon cancer slide using Catalog No:112300(LPCAT1 Antibody) at dilution of 1:100

Immunohistochemistry of paraffin-embedded human colon cancer slide using Catalog No:112300(LPCAT1 Antibody) at dilution of 1:100

Immunofluorescent analysis of MCF-7 cells, using LPCAT1 antibody Catalog No:112300 at 1:25 dilution and Rhodamine-labeled goat anti-rabbit IgG (red).

IP Result of anti-LPCAT1 (IP:Catalog No:112300, 3ug; Detection:Catalog No:112300 1:4000) with mouse brain tissue lysate 3600ug.
-
Background
LPCAT1, also named as AYTL2, PFAAP3 and LysoPAFAT, belongs to the 1-acyl-sn-glycerol-3-phosphate acyltransferase family. It is a key enzyme for remodeling phospholipids, including phosphatidylcholine. The expression level of LPCAT1 is able to differentiate prostate cancer from noncancerous prostatic changes, and correlates to the tumor grade of prostate cancer. LPCAT1 possesses both acyltransferase and acetyltransferase activities. It mediates the conversion of 1-acyl-sn-glycero-3-phosphocholine (LPC) into phosphatidylcholine (PC).
-
References
- Morita Y, Sakaguchi T, Ikegami K. Lysophosphatidylcholine acyltransferase 1 altered phospholipid composition and regulated hepatoma progression. Journal of hepatology. 59(2):292-9. 2013.
- Grupp K, Sanader S, Sirma H. High lysophosphatidylcholine acyltransferase 1 expression independently predicts high risk for biochemical recurrence in prostate cancers. Molecular oncology. 7(6):1001-11. 2013.
- Xu B, Gao L, Wang L. Effects of platelet-activating factor and its differential regulation by androgens and steroid hormones in prostate cancers. British journal of cancer. 109(5):1279-86. 2013.
- Dupont N, Chauhan S, Arko-Mensah J. Neutral lipid stores and lipase PNPLA5 contribute to autophagosome biogenesis. Current biology : CB. 24(6):609-20. 2014.
- Uehara T, Kikuchi H, Miyazaki S. Overexpression of Lysophosphatidylcholine Acyltransferase 1 and Concomitant Lipid Alterations in Gastric Cancer. Annals of surgical oncology. 23 Suppl 2:206-13. 2016.
- Shida-Sakazume T, Endo-Sakamoto Y, Unozawa M. Lysophosphatidylcholine acyltransferase1 overexpression promotes oral squamous cell carcinoma progression via enhanced biosynthesis of platelet-activating factor. PloS one. 10(3):e0120143. 2015.
- Lin S, Ikegami M, Moon C, Naren AP, Shannon JM. Lysophosphatidylcholine Acyltransferase 1 (LPCAT1) Specifically Interacts with Phospholipid Transfer Protein StarD10 to Facilitate Surfactant Phospholipid Trafficking in Alveolar Type II Cells. The Journal of biological chemistry. 290(30):18559-74. 2015.
- Helley MP, Abate W, Jackson SK, Bennett JH, Thompson SW. The expression of Toll-like receptor 4, 7 and co-receptors in neurochemical sub-populations of rat trigeminal ganglion sensory neurons. Neuroscience. 310:686-98. 2015.
Related Products / Services
Please note: All products are "FOR RESEARCH USE ONLY AND ARE NOT INTENDED FOR DIAGNOSTIC OR THERAPEUTIC USE"
